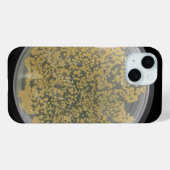
Coques Case-Mate iPhone Plaque de culture de bactéries recouverte de colon (Verso (horizontal))

40,60 €
par coque
Coques Case-Mate iPhone Plaque de culture de bactéries recouverte de colon
Voir les détails du produitA propos de Coques Case-mate
Vendu (e) par
À propos de ce design
Coques Case-Mate iPhone Plaque de culture de bactéries recouverte de colon
Une boîte de Pétri à gélose nutritive et beaucoup de belles colonies de bactéries adorables grace à ce téléphone très cultivé. Regardez toutes ces petites villes de micro-organismes. Ne sont-ils pas mignons ? Si vous avez dit oui, vous êtes juste la personne pour laquelle ce coque a été créé. Vous êtes un pro et vous pouvez prendre une boucle et faire des stries comme un maître. Regardez les gens regarder sur votre téléphone comme un grand point d'interrogation apparaît au-dessus de leur tête. Quand ils demandent "Qu'est-ce que c'est que ça ?", vous pouvez dire "c'est juste une petite culture." (peut-être ne dites-pas cela) Image copyright 2012 par Margaret E. Cmelik.
Traduction automatique
Avis des clients
5.0 sur 5 étoiles2 Nombres de Commentaires
2 Commentaires
Avis sur des produits similaires
5 sur 5 étoiles
Par C.31 août 2017 • Achat sécurisé
Coque téléphonique Case-Mate, iPhone 6/6s d'Apple, Tough
Programme d'évaluation de Zazzle
Coque GSM de très bonne qualité, avec l'impression que je me souhaitais. Top ! 😉. Impression de qualité, couleur nickel.... j'adore !!
5 sur 5 étoiles
Par fassin o.14 janvier 2021 • Achat sécurisé
Coque téléphonique Case-Mate, Apple iPhone 8/7/SE2/SE3, Barely There
Programme d'évaluation de Zazzle
très belle finition, cool, original. très bonne réalisation, très bonne impression
Tags
Autres infos
Identifiant du produit : 179340672627167670
Fabriqué le 07/02/2021 19:57
Évalué G
Articles vus récemment